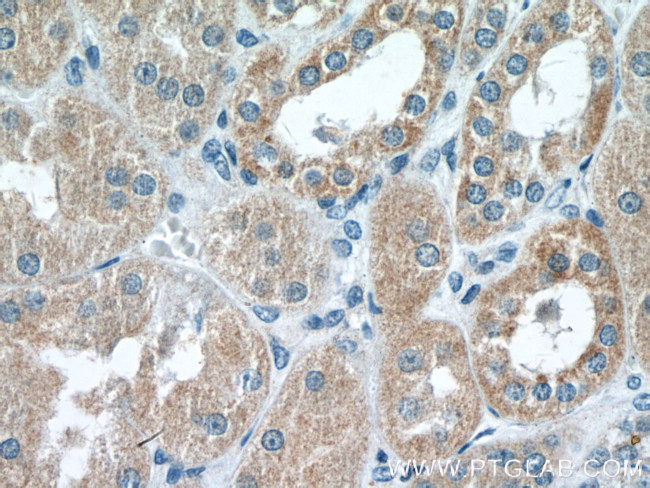
RAB11FIP3 Antibody in Immunohistochemistry (Paraffin) (IHC (P))

Search
Proteintech
RAB11FIP3 Polyclonal Antibody
{{$productOrderCtrl.translations['antibody.pdp.commerceCard.promotion.promotions']}}
{{$productOrderCtrl.translations['antibody.pdp.commerceCard.promotion.viewpromo']}}
{{$productOrderCtrl.translations['antibody.pdp.commerceCard.promotion.promocode']}}: {{promo.promoCode}} {{promo.promoTitle}} {{promo.promoDescription}}. {{$productOrderCtrl.translations['antibody.pdp.commerceCard.promotion.learnmore']}}
产品信息
25843-1-AP
种属反应
宿主/亚型
分类
类型
抗原
偶联物
形式
浓度
规格
纯化类型
保存液
内含物
保存条件
运输条件
产品详细信息
Immunogen sequence: CNGQLGCSD PAFLTPSPTK RLSSKKVARY LHQSGALTME ALEDPSPELM EGPEEDIADK VVFLERRVLE LEKDTAATGE QHSRLRQENL QLVHRANALE EQLKEQELRA CEMVLEETRR QKELLCKMER EKSIEIENLQ TRLQQLDEEN SELRSCTPCL KANIERLEEE KQKLLDEIES LTLRLSEEQE NKRRMGDRLS HERHQFQRDK EATQELIEDL RKQLEHLQLL KLEAEQRRGR SSSMGLQEYH SRARESELEQ EVRRLKQDNR NLKEQNEELN GQIITLSIQG AKSLFSTAFS ESLAAEISSV SRDELMEAIQ KQEEINFRLQ DYIDRIIVAI METNPSILEV K (407-756 aa encoded by BC051360)
靶标信息
Proteins of the large Rab GTPase family have regulatory roles in the formation, targeting, and fusion of intracellular transport vesicles. RAB11FIP3 is one of many proteins that interact with and regulate Rab GTPases (Hales et al., 2001 ).
仅用于科研。不用于诊断过程。未经明确授权不得转售。
生物信息学
蛋白别名: Arfophilin-1; cytoplasmic adaptor for RAR and TR; EF hands-containing Rab-interacting protein; Eferin; FIP3; FIP3-Rab11; medulloblastoma antigen; MU-MB-17.148; RAB11 family interacting protein 3 (class II); Rab11 family-interacting protein 3; rab11-family interacting protein 3; Rab11/25 binding-protein; unnamed protein product
基因别名: ARFO1; CART1; D030060O14Rik; FIP3; FIP3-Rab11; KIAA0665; LRRGT00043; mKIAA0665; Rab11-FIP3; RAB11FIP3; RGD1308952
UniProt ID: (Human) O75154, (Mouse) Q8CHD8
Entrez Gene ID: (Human) 9727, (Mouse) 215445, (Rat) 303002